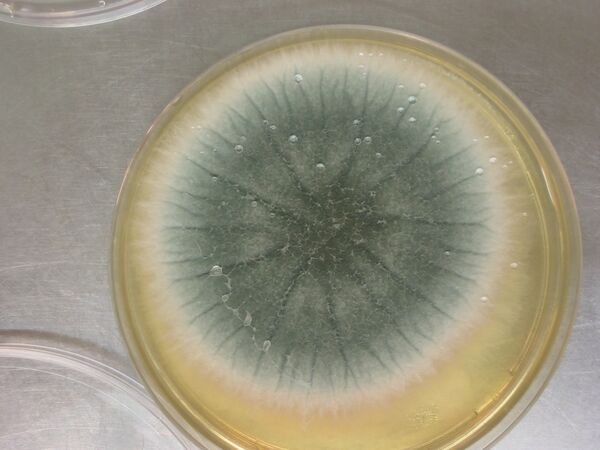

Глиотоксин
Глиотоксин — органическое соединение, серосодержащий микотоксин, производное 2,5-дикетопиперазина. Контаминант. Является вторичным метаболитом эпиполитиодиоксипиперазина и продуцируется некоторыми видами микромицетов родов Аспергилл, Триходерма и Пеницилл. Первоначально был выделен в 1936 году и изолирован из мицелия Gliocladium fimbriatum откуда и получил своё название. Структура была определена в 1958 году. Высокотоксичен. Обладает ярко выраженной цитотоксичностью, иммунносупрессор. Помимо этого обладает сильным бактериостатическим и бактерицидным воздействием. Ограниченно применяется в сельском хозяйстве в качестве фунгицида (в смесях с бензолом или керосином).
Что важно знать
| Глиотоксин | |
|---|---|
| Общие | |
| Систематическое наименование |
(3R,6S,10aR)-6-гидрокси-3-(гидроксиметил)-2-метил-2,3,6,10-тетрагидро-5aH-3,10a-эпидитиопиразино[1,2-a]индол-1,4-дион |
| Традиционные названия |
Глиотоксин, аспергеллин. |
| Хим. формула | C13H14N2O4S2 |
| Физические свойства | |
| Состояние | твёрдое кристаллическое вещество от белого до желтоватого цвета |
| Молярная масса | 326,398 г/моль |
| Плотность | 1,75 г/см³ |
| Термические свойства | |
| Температура | |
| • плавления | 200-202 °C |
| Классификация | |
| Рег. номер CAS | 67-99-2 |
| 3D model (JSmol) | Интерактивная схема |
| PubChem | 6223 |
| UNII | 5L648PH06K |
| CompTox Dashboard EPA | DTXSID60877179 |
| Рег. номер EINECS | 636-170-3 |
| SMILES | |
| InChI | |
| ChEBI | 5385 |
| ChemSpider | 5988 |
| ECHA InfoCard | 100.163.992 |
| Безопасность | |
| ЛД50 |
45 мг/кг (кролик, внутривенно), 67 мг/кг (мышь, перорально) |
| Токсичность | Высокотоксичен, сильный иммунносупрессор, обладает цитотоксичностью. |
| Фразы риска (R) | R25 |
| Фразы безопасности (S) | S36 S37 |
| Краткие характер. опасности (H) |
H301 |
| Меры предостор. (P) |
P301, P310 |
| Пиктограммы СГС |
|
Источники
Источниками глиотоксина являются некоторые микроскопические грибы-продуценты микотоксинов рода Аспергилл (главным образом патогенный для человека Aspergillus fumigatus или Аспергилл дымящий[1]), Триходерма (Trichoderma veride, T.lignorum) и Пеницилл (Penicillium obscurum). Также сообщалось о возможной продукции глиотоксина грибами рода Кандида (Candida)[2] , однако, результаты других исследований поставили под сомнение производства этого метаболита грибов рода Candida[3][4] .
Физико-химические свойства
Представляет собой белое или слегка желтоватое вещество кристаллизующеся вв виде небольших игл. Нерастворимое в воде и тетрахлорметане, хорошо растворяется в органических растворителях — хлороформе, бензоле, ацетоне и особенно в ДМСО, диоксане и пиридине. Оптически активен. При температурах свыше 200° С происходит быстрое разрушение структуры. Устойчив в кислой среде. Легко разрушается действием щелочей.
Токсикология
Глиотоксин проявляет иммуносупрессивные свойства, так как он может подавлять и вызывать апоптоз в некоторых типах клеток иммунной системы, в том числе нейтрофилов, эозинофилов, гранулоцитов, макрофагов и тимоцитов. Он также действует как ингибитор фарнезил-трансферазы. Он необратимо ингибирует химотрипсин-подобную активность 20S протеаосом.
Интоксикация глиотоксином проявляется в виде аспергиллофумигатотоксикоза. Существует острая и хроническая форма.
Глиотоксин как антибиотик
У глиотоксина хорошо выражены антибиотические свойства в особенности на грамположительные виды бактерий. На грамотрицательные бактерии он действует слабо. Глиотоксин также способен подавлять и рост Mycobacterium tuberculosis. Также обладает высокой противогрибковой активностью. Однако практического применения в качестве антибиотика он не имеет, вследствие его чрезвычайно высокой токсичности ЛД100 при внутрибрюшинном введении мыши 5 мг/кг, при пероральном введении он высокотоксичен (ЛД50 = 67 мг/кг, мыши).